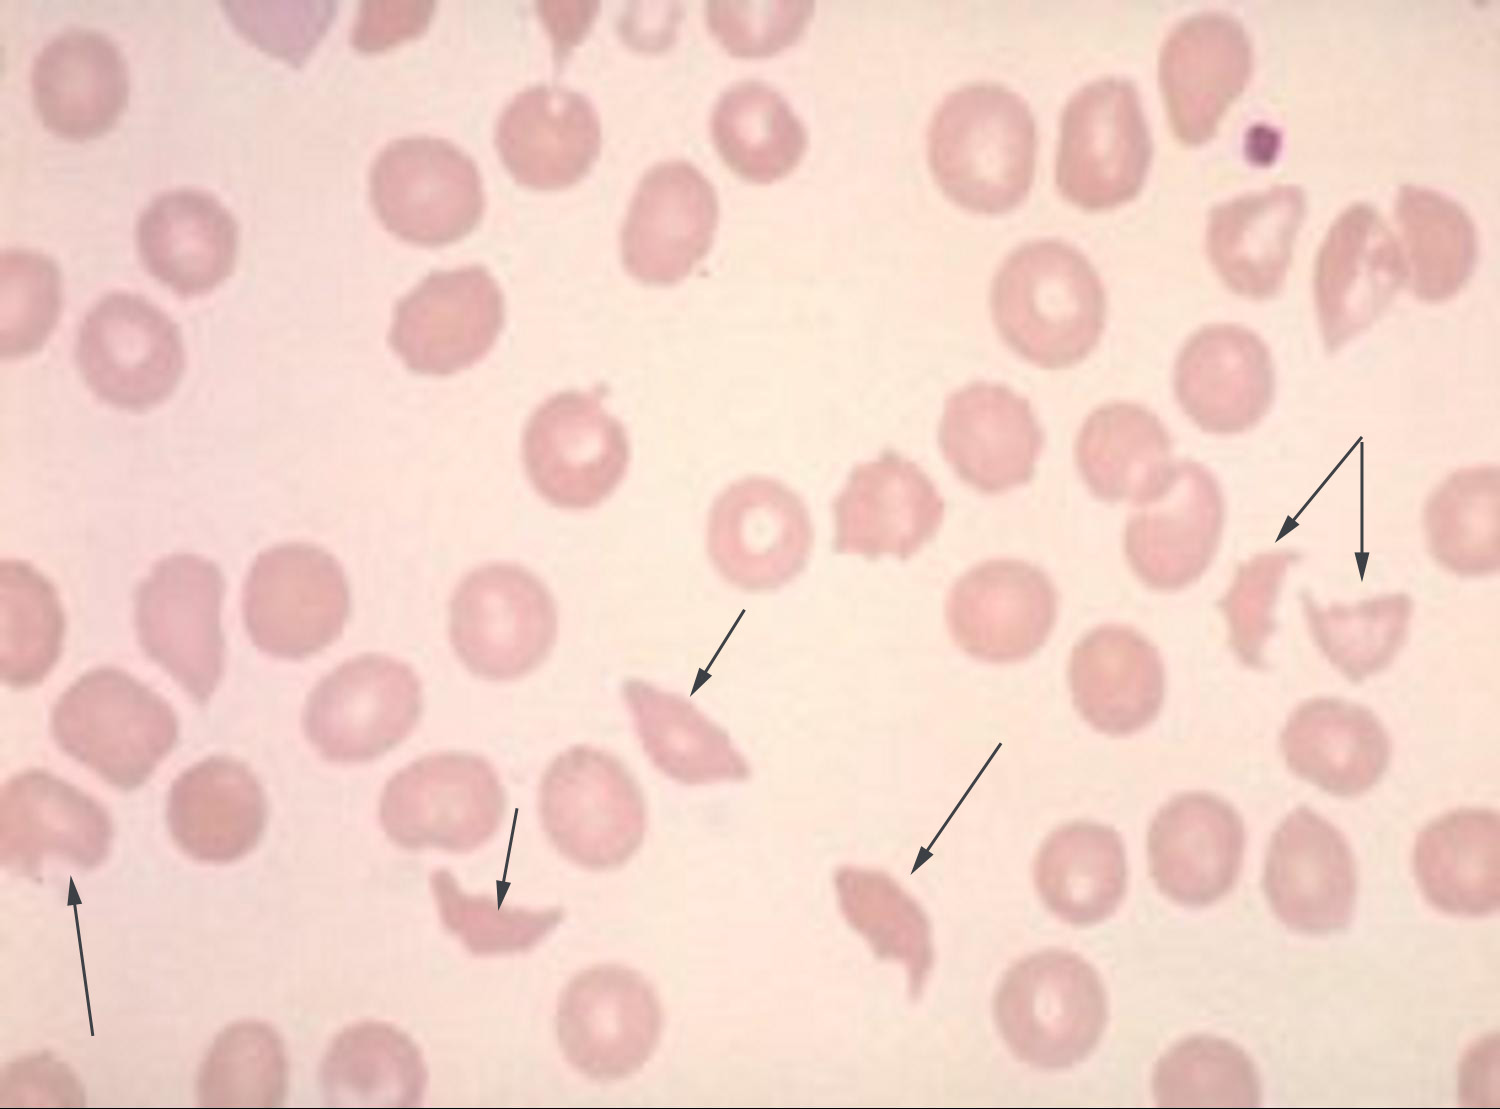
fragmenterede erytrocytter ved ttp jpg

Fragmenterede erytrocytter ved TTP
Fragmenterede erytrocytter ("æbleskrog" som pilene peger på) ved trombotisk trombocytopenisk purpura (TTP).
Indhold leveret af
Patienthåndbogen
laegehaandbogen@dadl.dk
Patienthåndbogen
Kristianiagade 12
2100 København Ø
Disclaimer: Patienthåndbogen